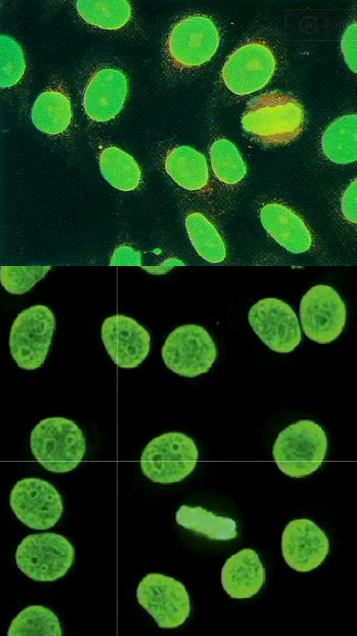

Criteria required for diagnosis of lupus
4 of 8 criteria: 1) Malar rash 2) Discoid rash 3) Photosensitivity 4) Oral ulcers 5) Non-erosive Arthritis 6) Serositis (pleuritis and pericarditis) 7) Renal disorder (massive proteinuria) 8) Neurologic disorder (seizures and psychosis) 9) Hematologic disorder (hemolytic anemia) 10) Immunologic disorder (Anti-ds DNA, anti-Smith, anti-phospholipid, lupus anticoagulant, anti-cardiolipin) 11) Antinuclear antibody seen in 100% of Lupus proteins
Why is it important to note that the malar rash of lupus spares the nasolabial folds?
Seborrheic dermatitis does not spare the nasolabial folds
Antibodies that are highly specific for lupus
Anti-ds DNA (associated with lupus nephritis) and anti-smith antibodies.
Antibodies seen in lupus and Sjogren’s syndrome
Anti-SS-A (Ro) and anti-SS-B (La) antibodies, note that when associated with lupus it is typically subacute cutaneous lupus
What are ANAs targeted against?
DNA, histones, non-histone proteins bound to RNA and nucleolar antigens.
Antibodies that are commonly seen in drug-induced lupus
Anti-histone antibodies
How do we determine if a patient has ANAs?
Incubate patient’s serum overnight -> Add fluorescing anti-IgG antibody that glows if ANAs are present.
Immunohistochemical analysis of a patient with suspected lupus is shown below. What are the likely antibodies present in this patient’s serum and what diseases are they associated with?
Homogenous pattern = anti-histone (drug-induced lupus) and anti-dsDNA (SLE)
Immunohistochemical analysis of a patient with suspected lupus is shown below. What are the likely antibodies present in this patient’s serum and what diseases are they associated with?

Peripheral (rim) pattern = anti-dsDNA (SLE w/renal involvement). Note that his is highly specific for SLE.
Immunohistochemical analysis of a patient with suspected lupus is shown below. What are the likely antibodies present in this patient’s serum and what diseases are they associated with?

Speckled pattern = anti-smith, anti-RNP, anti-SSA(Ro), anti-SSB(La) antibodies against ribonucleoproteins. These are not highly specific, but are associated with SLE, RA, systemic sclerosis and Sjogren syndrome.
How can we follow disease activity in patients with lupus?
Anti-dsDNA titers fluctuate parallel with disease activity
Immunohistochemical analysis of a patient with suspected lupus is shown below. What are the likely antibodies present in this patient’s serum and what diseases are they associated with?

Nucleolar pattern = anti-topoisomerase I and anti-SCL-70 antibodies associated with diffuse systemic sclerosis.
Immunohistochemical analysis of a patient with suspected lupus is shown below. What are the likely antibodies present in this patient’s serum and what diseases are they associated with?

Centromere pattern = anti-centromere antibody against the kinetochore that is associated with limited scleroderma (CREST syndrome)
Antibodies that are present in 30-40% of lupus patients that target prothrombin, annexin V, B2 glycoprotein I and protein C/S? What other condition will these be present in?
Anti-phospholipid antibodies. Antibodies to phospholipid-beta2 glycoprotein bind cardiolipin and result in a false positive test for syphilis (+VDRL with a - FTA-ABS).
People at highest risk for SLE
Females in childbearing years (2-4th decade)
What alleles are associated with anti-dsDNA, anti-Sm antibodies?
HLA-DQ
Complement deficiencies that may contribute to development of lupus
C2, C4 or C1q: deficiency results in failure to clear immune complexes and apoptotic cells that results in immunogenicity of apoptotic debris. Note that there is a lupus genetic component, but the environmental component is the largest factor.
Environmental triggers for lupus
UV light: induces keratinocyte apoptosis and IL-1 release which can generate anti-nuclear antibodies. Females: sex hormones/genes on X chromosome. Drugs: hydralazine, procainamide, D-penicillamine and INH (isoniazid for Tb).
What differentiates drug induced lupus from SLE?
There is no renal involvement
How does self tolerance fail in lupus?
Pathogenic IgG antibodies = CD4+ T-cell and B-cell peripheral tolerance impairment. TLR activation by DNA/RNA immune complex promotes expansion of autoreactive B cells. Type I IFN: produced in response to immune complex binding to TLRs on dendritic cells -> production of IFN-alpha. Increased BAFF increases B cell survival.
Belumimab
Anti-BAFF used to decrease B-cell survival in patients with lupus.
Pathogenic model for lupus
Susceptibility genes impair self tolerance and produce B and T cells specific for self nuclear antigens -> external environmental agent triggers increased burden of nuclear antigens -> ANA-antigen complex endocytosis, nuclear antigen engages TLRs -> Stimulation of B-cells and dendritic cells -> Release of type 1 IFNs -> Stimulation of B cells and T cells -> Persistent high levels of ANA IgG

What mediates tissue injury in lupus?
Immune complex deposition in glomeruli, small blood vessels and blood brain barrier. This causes fixation of complement and inflammation. Anti-RBC/WBC/Platelet antibodies bind to hematopoietic elements directly, complement fixes and hemolytic anemia ensues.
Cells you might see that are indicative of lupus
LE cells: apoptosis allows ANA to bind nuclei, fix complement and attract PMNs and macrophages to engulf them. This results in nuclear material within the phagocytes.














